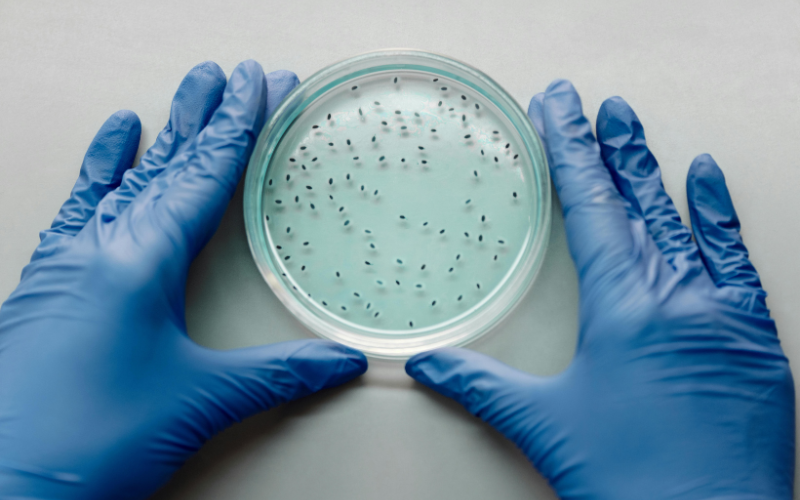

Superbactérias e resistência ao tratamento com antibióticos
A disseminação das superbactérias e resistência ao tratamento com antibióticos é uma das maiores ameaças à saúde pública global. Segundo a Organização Mundial da Saúde (OMS), a resistência antimicrobiana é hoje uma das dez principais ameaças à saúde no planeta, responsável por aproximadamente 1,27 milhão de mortes por ano diretamente associadas a infecções resistentes ¹.
Em um mundo em que procedimentos médicos complexos — como cirurgias, quimioterapia e transplantes — dependem da eficácia dos antibióticos, perder essa ferramenta terapêutica representa um risco grave para a medicina moderna.
Sendo assim, quando uma bactéria se torna resistente aos medicamentos que antes a eliminavam, o tratamento das infecções se torna mais difícil, mais caro e, em muitos casos, ineficaz. A resistência antimicrobiana, portanto, não é apenas um problema científico, mas também um desafio social, econômico e ético⁴.
O que são superbactérias?
O termo “superbactérias” se refere a micro-organismos que desenvolveram resistência a múltiplas classes de antibióticos, sendo chamadas de bactérias multirresistentes.
Essa resistência ocorre naturalmente por mutações genéticas, mas tem sido acelerada pelo uso indiscriminado e inadequado de antibióticos em humanos, animais e no meio ambiente³.
Portando, quando um antibiótico é utilizado de forma incorreta — seja por automedicação, abandono precoce do tratamento ou prescrição desnecessária — as bactérias mais fortes sobrevivem e se multiplicam, passando adiante os genes de resistência. Com o tempo, isso cria cepas bacterianas cada vez mais difíceis de combater.
Como a resistência aos antibióticos acontece?
A resistência bacteriana é um processo evolutivo. As bactérias podem:
- Alterar a estrutura de suas células, impedindo que o antibiótico se ligue ao alvo;
- Produzir enzimas que degradam o antibiótico;
- Expulsar o medicamento antes que ele atue, por meio de bombas de efluxo;
- Trocar genes de resistência entre si, até mesmo entre espécies diferentes, acelerando a disseminação do problema².
Esses mecanismos tornam as infecções persistentes e de tratamento cada vez mais complexo.
Principais causas do aumento da resistência
A OMS alerta que estamos entrando em uma era em que infecções simples podem voltar a ser fatais. Entre as principais causas do aumento da resistência estão:
- Uso excessivo e inadequado de antibióticos
O consumo desnecessário — especialmente sem prescrição médica — é um dos principais fatores de risco. Muitos ainda acreditam que antibióticos curam resfriados ou gripes, doenças virais que não respondem a esse tipo de medicamento ¹. - Interrupção precoce do tratamento
Parar o antibiótico assim que os sintomas melhoram permite que as bactérias sobreviventes, mais resistentes, se multipliquem. - Uso de antibióticos na agropecuária
A utilização desses medicamentos para promover o crescimento de animais e prevenir doenças em rebanhos é uma das principais fontes de disseminação de resistência⁴. - Falta de saneamento e controle de infecções
Ambientes hospitalares e comunitários com higiene inadequada facilitam a propagação de microrganismos resistentes³. - Baixo investimento em novos antibióticos
O desenvolvimento de novos medicamentos tem diminuído nas últimas décadas. Apenas um pequeno número de novos antibióticos foi aprovado nos últimos 30 anos, e a maioria pertence a classes antigas, já conhecidas pelas bactérias.
As superbactérias mais conhecidas
Algumas bactérias têm se destacado por seu alto nível de resistência e pela gravidade das infecções que causam:
- Staphylococcus aureus resistente à meticilina (MRSA) – causa infecções de pele, pulmonares e septicemias difíceis de tratar.
- Klebsiella pneumoniae e Escherichia coli produtoras de ESBL – resistentes a penicilinas e cefalosporinas, e responsáveis por infecções urinárias e hospitalares.
- Pseudomonas aeruginosa – comum em ambientes hospitalares e particularmente perigosa em pacientes imunossuprimidos.
- Acinetobacter baumannii – associada a infecções pulmonares e urinárias em UTIs.
- Enterococcus faecium resistente à vancomicina (VRE)** – provoca infecções graves em pacientes hospitalizados².
Essas superbactérias estão presentes tanto em hospitais quanto em ambientes comunitários, tornando o controle um desafio global.

Consequências da resistência antimicrobiana
A resistência a antibióticos tem impacto direto sobre a saúde pública, os sistemas hospitalares e a economia mundial:
- Aumento da mortalidade e do tempo de internação – infecções resistentes prolongam tratamentos e elevam o risco de complicações e óbitos.
- Custos hospitalares mais altos – pacientes com infecções resistentes demandam medicamentos mais caros e longas estadias hospitalares.
- Risco em procedimentos médicos – sem antibióticos eficazes, cirurgias simples e quimioterapia tornam-se arriscadas.
- Impactos econômicos globais – o Banco Mundial alerta que, até 2050, a resistência antimicrobiana pode causar perdas econômicas de até 100 trilhões de dólares e empurrar 28 milhões de pessoas para a pobreza extrema.
O que pode ser feito para conter as superbactérias?
O combate à resistência ao tratamento com antibióticos exige ação coordenada em múltiplos níveis: individual, clínico e político.
1. Uso racional de antibióticos
A principal regra é usar antibióticos apenas quando prescritos por um profissional de saúde.
Nunca utilize sobras de tratamentos anteriores e siga as orientações médicas até o fim do tratamento. O uso racional reduz a seleção de bactérias resistentes e mantém a eficácia dos medicamentos³.
2. Controle de infecções
Higienização correta das mãos, vacinação, esterilização de instrumentos e isolamento de pacientes infectados são medidas simples, mas extremamente eficazes no controle da disseminação de superbactérias⁴.
3. Diagnóstico rápido
A ampliação do acesso a testes laboratoriais e tecnologias de diagnóstico rápido permite identificar o agente infeccioso e selecionar o antibiótico mais adequado, reduzindo o uso empírico e desnecessário de medicamentos.
4. Pesquisa e inovação
Investir em novas classes de antibióticos e terapias alternativas é essencial. Pesquisas com bacteriófagos, imunoterapias e compostos que inibem mecanismos de resistência estão em andamento em centros internacionais de referência.
5. Políticas públicas e vigilância
Programas nacionais de vigilância da resistência antimicrobiana ajudam a monitorar surtos e orientar políticas públicas. No Brasil, o Plano de Ação Nacional para Prevenção e Controle da Resistência aos Antimicrobianos reforça a integração entre vigilância, diagnóstico e uso racional de antibióticos³.
O papel da sociedade
Cada pessoa tem um papel importante na prevenção da resistência bacteriana:
- Não usar antibióticos sem receita médica;
- Cumprir corretamente o tratamento prescrito;
- Evitar o descarte inadequado de medicamentos;
- Manter hábitos de higiene e vacinação atualizados;
- Apoiar campanhas de conscientização sobre o uso racional de antibióticos.
Sendo assim, a conscientização é uma das ferramentas mais poderosas na luta contra as superbactérias e resistência ao tratamento com antibióticos. Quando todos compreendem a gravidade do problema e fazem sua parte, é possível conter a evolução da resistência e preservar a eficácia dos medicamentos que salvam vidas.
Conclusão
A resistência ao tratamento com antibióticos é uma ameaça silenciosa, mas crescente. O avanço das superbactérias pode colocar em risco décadas de progresso médico.
Porém, a boa notícia é que ainda há tempo para agir — com informação, responsabilidade e colaboração entre governos, profissionais e cidadãos.
O uso consciente de antibióticos, aliado à pesquisa e à inovação, é o caminho para garantir um futuro onde as infecções continuem sendo tratadas de forma segura e eficaz.
Continue navegando pelo Blog para ver mais dicas para sua saúde e bem-estar!
Referências:
1- Organização Mundial da Saúde (OMS)
2- Centers for Disease Control and Prevention (CDC)








